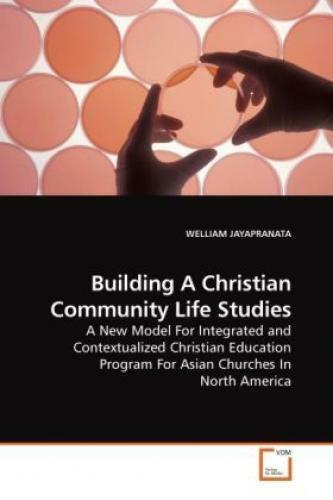

Building A Christian Community Life Studies A Model For Integrated And
Finden Sie Building A Christian Community Life Studies A Model For Integrated And bei eBay in der Kategorie Bücher & Zeitschr... Mehr erfahren
Finde die besten Angebote
Bester Preis

ebay
Versand: 2,94 €
Lieferzeit: 4-6 Werktage
Versand: 2,94 € | Lieferzeit: 4-6 Werktage
Ähnliche Produkte
Produktdetails
Finden Sie Building A Christian Community Life Studies A Model For Integrated And bei eBay in der Kategorie Bücher & Zeitschriften:Fachbücher, Lernen & Nachschlagen:Studium & Erwachsenenbildung.
Informationen
Lieferzeit:4-6 Werktage














